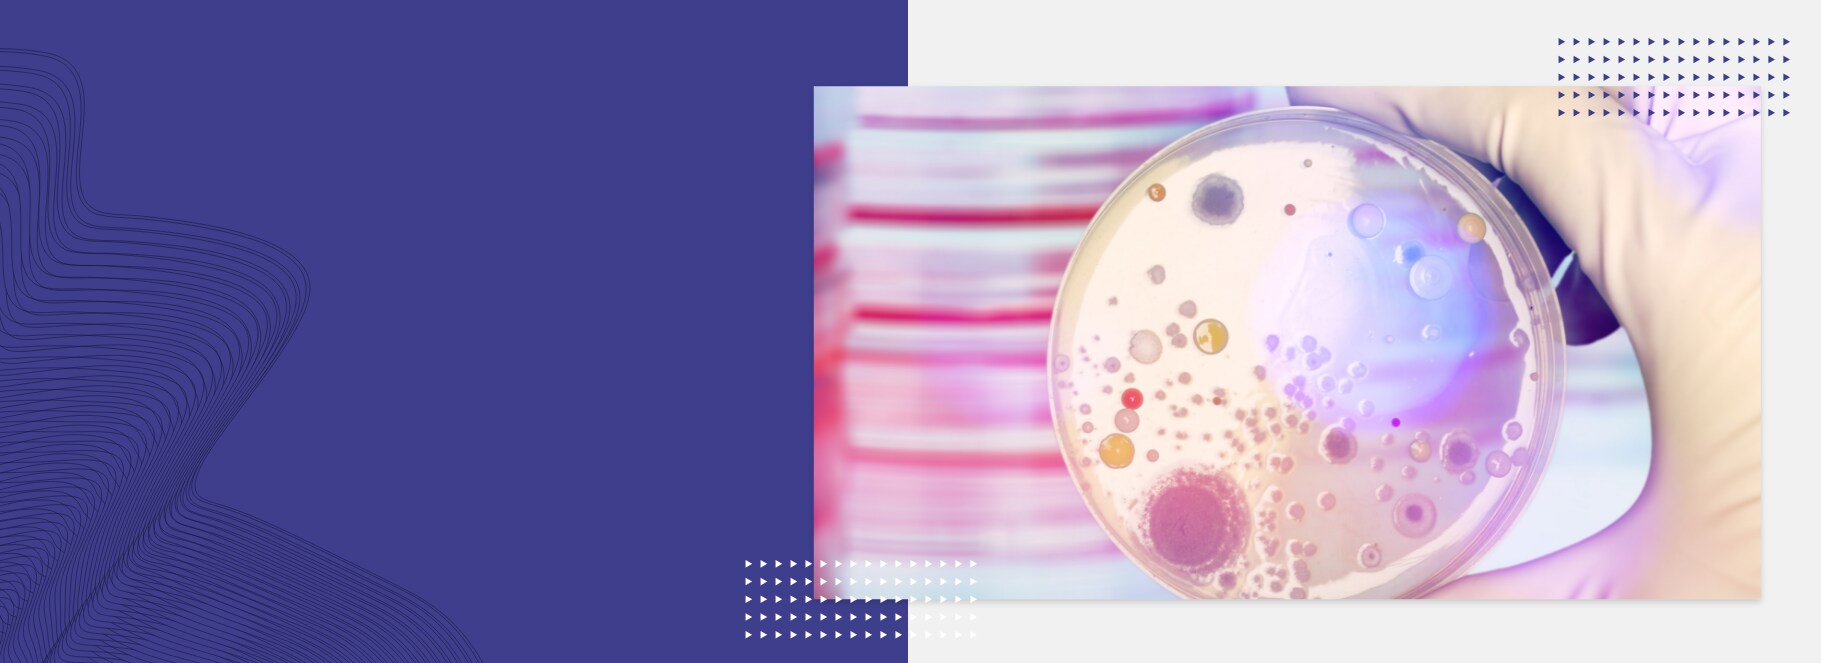
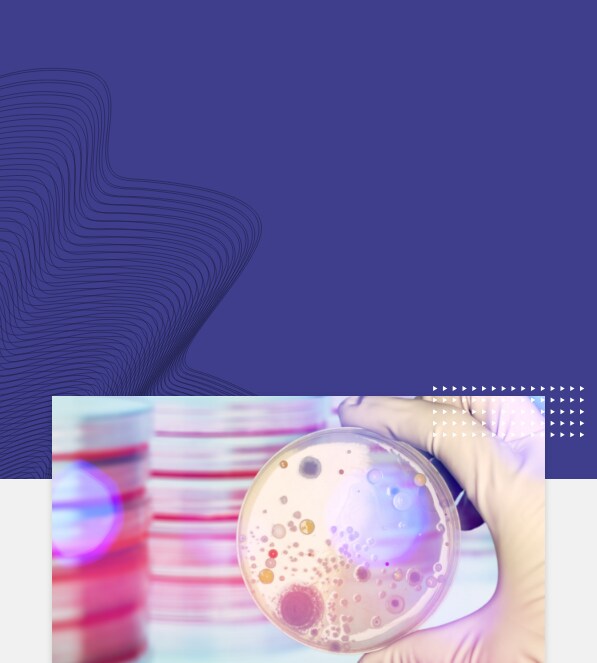
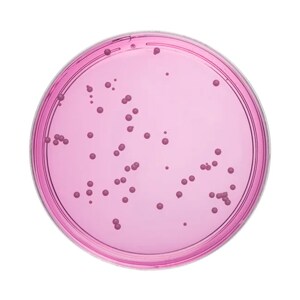
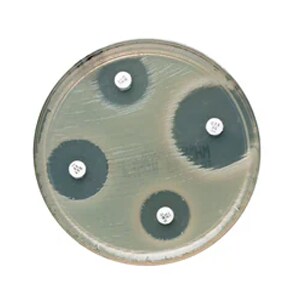
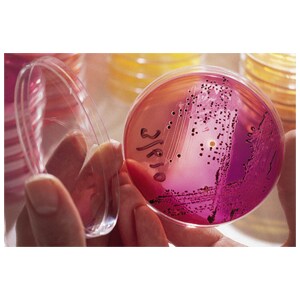

Tiny World, Big Discounts
Explore our extensive range of microbiology essentials and seize the opportunity to enjoy substantial discounts on everything you need, from sample collection to microbial identification, colony counting, and sample storage.
Unlock exclusive promotional prices by using promo code 21654, valid until 31st May, 2024, for over 1400 microbiology products.
Choose from our diverse categories to access discounts of up to 60%:

Dehydrated Microbiology Media
Prepared Microbiology Media

Media Additives

Counters for Microbiology

Inoculating Loops and Needles

Plastic Petri Dishes

Microbiological Analysis Filters

Microbiology Stains Dyes and Indicators

Food Testing Microbiology Supplies

General Microbiology Quality Control Products
Susceptibility Testing
Microbiology Environmental Systems

Microbiological Specimen Transport and Collection Kits

Class II Biosafety Cabinets (EN 12469 Certified)

Refrigerated Incubators

Standard Incubators